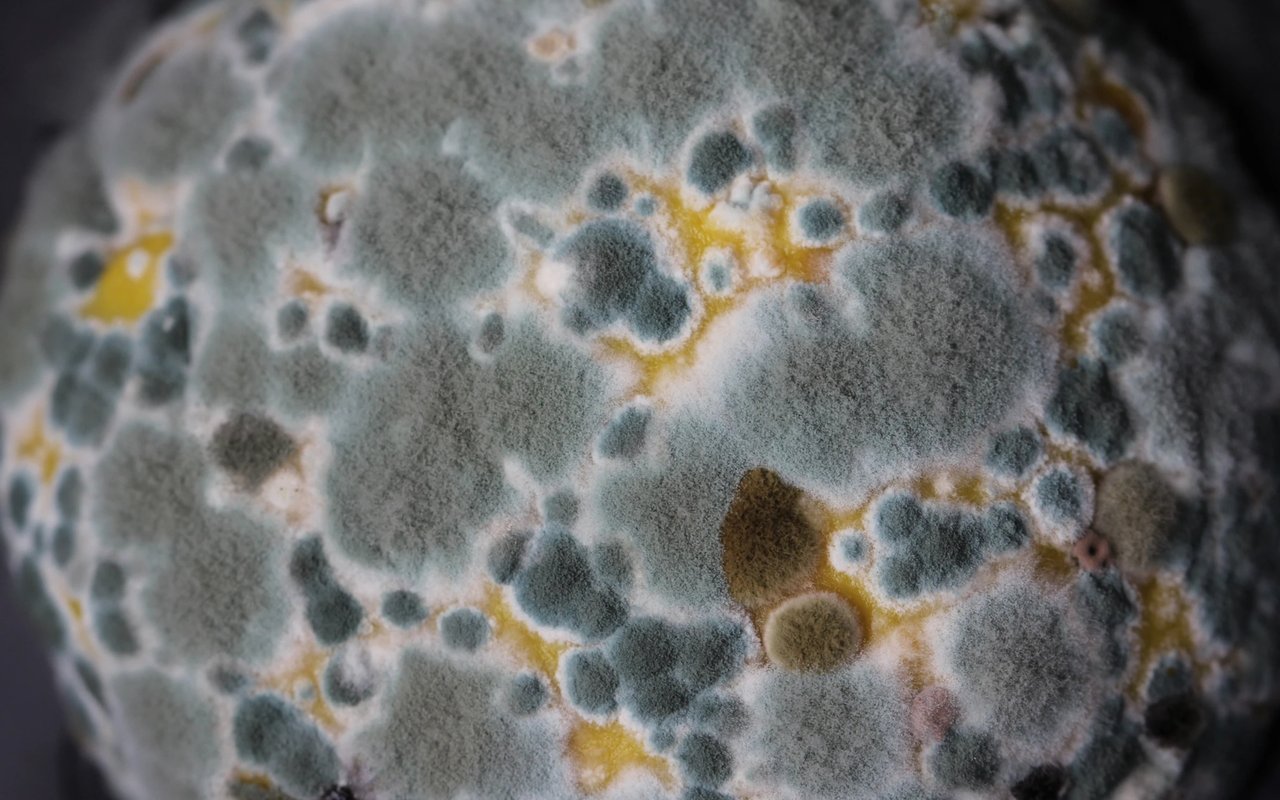
A Breath of Fresh Air: Mold Abatement When Purchasing a New Home

Buying a new home is an exciting journey, filled with the promise of fresh beginnings and new memories. However, it's essential to ensure that your dream home doesn't come with hidden issues, particularly when it comes to mold. Mold can be a serious concern for homeowners, causing health issues and structural damage if left unchecked. In this blog, we'll explore the importance of mold abatement when purchasing a new home and offer valuable insights into how to navigate this critical aspect of the home-buying process.
Understanding the Mold Menace
Mold is a type of fungus that thrives in damp and humid environments. It reproduces through spores that can spread easily through the air, leading to its presence in various areas of a home. While some molds are harmless, others can cause health problems such as allergies, respiratory issues, and even more severe conditions in vulnerable individuals. Mold can also compromise the structural integrity of a building, leading to costly repairs down the line.
The Importance of Mold Inspection
Before finalizing a home purchase, it's crucial to have a thorough mold inspection conducted by professionals. Even if the property looks immaculate, hidden mold issues might exist within walls, ceilings, and crawl spaces. A certified mold inspector will identify potential trouble spots and conduct tests to determine if mold is present. This step is especially critical if the home is located in an area with a humid climate or has a history of water damage.
Addressing Mold Abatement
If the mold inspection reveals the presence of mold, don't panic. Mold abatement is the process of safely removing and preventing the recurrence of mold growth. A professional mold remediation company should be brought in to assess the extent of the issue and develop a comprehensive plan to eliminate the mold problem. This process typically involves containment of the affected area, removal of contaminated materials, thorough cleaning, and the implementation of preventive measures.
Negotiating with Sellers
If mold is found during the inspection, you'll need to decide how to proceed with the purchase. In some cases, the seller may be willing to cover the cost of mold abatement as part of the negotiation process. Alternatively, you might ask for a reduction in the home's price to offset the expense of mold remediation. Remember that open communication is key; discussing the issue with the seller can lead to a mutually beneficial solution.
Preventive Measures for the Future
Once the mold issue has been successfully abated, it's essential to take preventive measures to avoid its return. Proper ventilation, maintaining optimal indoor humidity levels, and addressing any leaks or water damage promptly are essential steps. Regular inspections and maintenance can help ensure that your new home remains mold-free and a safe environment for you and your family.
In Conclusion
Mold abatement is a crucial consideration when purchasing a new home. A thorough mold inspection and professional remediation, if necessary, will help you avoid potential health risks and costly repairs in the future. Remember that transparency and communication with the seller are vital during this process. By prioritizing mold abatement, you're investing in the long-term health and wellbeing of your family and the future value of your new home.
#mold #sellingmyhouse #sellmyhouse #moldabatement #waterunderthehouse #Realtor #AndersonSC